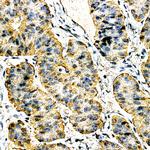
Calcitonin Antibody in Immunohistochemistry (Paraffin) (IHC (P))

Search
AbboMax
Calcitonin Polyclonal Antibody
{{$productOrderCtrl.translations['antibody.pdp.commerceCard.promotion.promotions']}}
{{$productOrderCtrl.translations['antibody.pdp.commerceCard.promotion.viewpromo']}}
{{$productOrderCtrl.translations['antibody.pdp.commerceCard.promotion.promocode']}}: {{promo.promoCode}} {{promo.promoTitle}} {{promo.promoDescription}}. {{$productOrderCtrl.translations['antibody.pdp.commerceCard.promotion.learnmore']}}
图: 1 / 1
Calcitonin Antibody (500-1154) in IHC (P)
产品信息
500-1154
种属反应
宿主/亚型
分类
类型
抗原
偶联物
形式
浓度
规格
纯化类型
保存液
内含物
保存条件
运输条件
产品详细信息
Positive control: Human thyroid medullary carcinoma
Cellular location: Cytoplasmic and Secreted.
靶标信息
Calcitonin is a 32 amino acid peptide which can be demonstrated in C cells of the normal and hyperplastic thyroid. Staining for calcitonin may be used for the identification of a spectrum of C cell proliferative abnormalities ranging from C cell hyperplasia to invasive tumors. Staining for calcitonin in medullary carcinoma of the thyroid produces a fine granular pattern in the cytoplasm. Amyloid deposits within the tumor may also exhibit varying degrees of calcitonin activity.
仅用于科研。不用于诊断过程。未经明确授权不得转售。
篇参考文献 (0)
生物信息学
蛋白别名: Alpha CGRP; Alpha type CGRP; Alpha-type CGRP; Calcitonin; calcitonin 1; calcitonin gene related peptide 1; calcitonin gene related protein; Calcitonin gene-related peptide 1; Calcitonin gene-related peptide I; calcitonin precursor; calcitonin/calcitonin-related polypeptide, alpha; CGRP-I; CGRP1; katacalcin; katacalcin (KC); prepro-alpha-calcitonin gene-related peptide; unnamed protein product
基因别名: CA; Cal1; CAL6; CALC; CALC1; CALCA; calcitonin; CCALCI; CGRP; CGRP-1; CGRP-alpha; CGRP-I; CGRP1; CT; Ctn; KC; PCT; RATCAL6
UniProt ID: (Dog) Q9MYV1, (Human) P06881, (Rat) P01256, (Mouse) Q99JA0
Entrez Gene ID: (Dog) 403946, (Human) 796, (Rat) 24241, (Mouse) 12310



